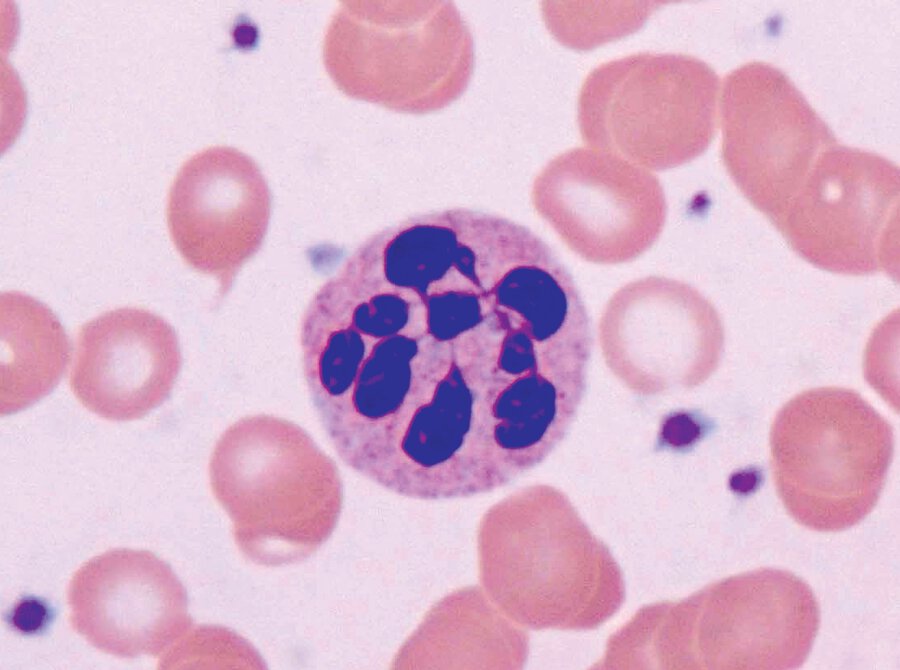

The antibody associated with membranous nephropathy
Anti-phospholipase A2 receptor
The name for this discoloration

Allergic Shiner
The equation to calculate an anION gap
Na - (Cl + HCO3)
In half of patients with LAMbert-Eaton myasthenic syndrome, malignancy is found, especially this cancer.
small cell lung cancer
Gotta fix that calendar I have that's marked July 15th
"So Sick" by Ne-Yo
Amyloidosis pathology findings
Stains apple green with congo red stain
history (confirmed with empiric treatment) only if empiric treatment fails do you do diagnostic allergy testing
<3 Dev Patel <3
This finding may occur in patients with this deficiency
cobaLAMin deficiency (B12)
Between the lines of fear and blame
You begin to wonder why you came
Where did I go wrong? I lost a friend
"How to save a life" by The Fray
A medication for ADPKD that has showed a reduction the rate of increase in kidney size and loss of GFR, but poor tolerance, hepatotoxicity, and expense limit its use
Tolvaptan
This disease is commonly associated with dysphagia and food bolus obstruction and patients often have asthma, dermatitis, and seasonal/food allergies.
Eosinophilic esophagitis
The reason you should not give a Ca+ channel blocker in a patient with aortic dissection without beta blockade
Without beta blockade vasodilatory therapy induces reflex activation of the sympathetic nervous system resulting in tachycardia and enhanced ventricular contraction, which increases aortic wall sheer stress
This infLAMmatory dermatosis is T-cell mediated and presents as pruritic, flat-topped, violaceous papules, often on the ankles and wrists and mucous membranes

Lichen Planus
How could you be so, cold as the winter wind when it breeze, yo
Just remember that you talkin' to me though
You need to watch the way you talkin' to me, yo
"Heartless" by Kanye West
Medical expulsive therapy for nephrolithiasis for:
1. Stones < 5mm
2. Stones >5 and <10mm
3. Stones >10mm
1. Stones < 5mm
- No medical expulsive therapy indicated
2. Stones >5 and <10mm
- Tamsulosin for 4 weeks (if unavailable, use alpha blocker)
3. Stones >10mm
- Refer to urology for intervention
Treatment for acute sinusitis with persistent symptoms of >10 days duration
First Line: Amoxicillin-clavulanate or amoxicillin
Second Line: doxycycline, Levofloxacin or moxifloxacin, clindamycin
This medication, that blocks epithelial Na channels in the collecting tubule is the treatment for a patient who recently started lithium for bipolar disorder now presents with polyuria and nocturia. Na is 145 and Uosm is 200.
This medication started after this many weeks of pregnancy reduces rates of preeLAMpsia in women who are high risk.
Low dose ASA (81mg) after 12 weeks
But how do you expect me
To live alone with just me?
'Cause my world revolves around you
It's so hard for me to breathe
"No Air" by Jordan Sparks
A malignancy in post-transplant patient that is caused by uncontrolled B-lymphocyte proliferation associated with Epstein-Barr virus infection and impaired T-cell surveillance
Posttransplant lymphoproliferative disorders
Patients with this disease often have comorbid allergies or asthma, organ enlargement, and storiform fibrosis on biopsy.
IgG4 related disease
In patients with MS and ambulatory dysfunction, this medication can improve gait speed and endurance. It is an oral voltage-gated K+ channel antagonist.
Dalfampridine
This skin condition under Wood LAMp reveals coral red fluorescence

Erythasma
Where I'm weak? Baby, I couldn't breathe
And rub it in so deep
Salt in the wound like you're laughing right at me
"Bad Blood" by Taylor Swift